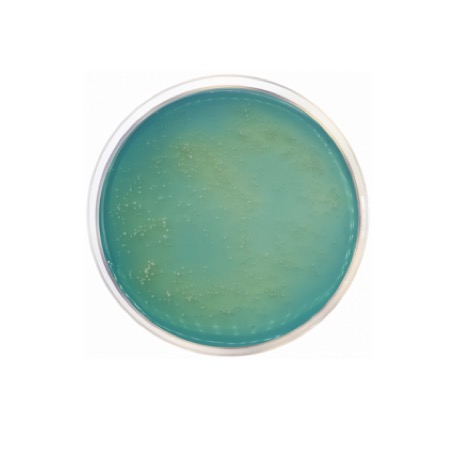
product

MYP Agar relies on three specific characteristics to differentiate Bacillus cereus from other species. First, Mannitol is included as a fermentable carbohydrate; B. cereus is mannitol-negative, so it does not produce acid, and the Phenol Red indicator remains pink/red. Second, the addition of Egg Yolk Emulsion allows for the detection of lecithinase activity; B. cereus produces this enzyme, resulting in a distinct zone of precipitation around the colonies. Third, selectivity is achieved by the addition of Polymyxin B, which inhibits the growth of most Gram-negative bacteria and some Gram-positive organisms without affecting B. cereus at the recommended concentrations.
Advantages
- Effective Differentiation: The combination of mannitol non-fermentation and lecithinase production provides a clear visual identification of B. cereus.
- High Selectivity: Polymyxin B effectively suppresses background microflora, especially Gram-negative species like Escherichia coli and Pseudomonas.
- Standardized Methodology: Frequently cited in official methods for the analysis of dairy, meat, and dried food products.
- Clear Visual Contrast: Large, pink/red colonies surrounded by a zone of egg yolk precipitation are easily distinguishable from mannitol-fermenting organisms (which turn yellow).
- Robust Recovery: The nutrient base is optimized to support the recovery of stressed spores common in processed food samples.
Technical specifications
| Catalogue number |
0945 |
| Brand |
Condalab |
| Application |
Isolation and enumeration of Bacillus cereus |
| Typical Composition (g/L) |
Beef Extract (1.0); Peptone (10.0); D-Mannitol (10.0); Sodium Chloride (10.0); Phenol Red (0.025); Bacteriological Agar (12.0) |
| Final pH (at 25 °C) |
7.2 ± 0.2 |
| Preparation |
43.0 g/L (plus supplements) |
| Storage Temperature |
2 – 25 °C |
Available packaging options
| 0945 |
500 g plastic bottle |